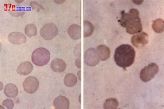
異形紅細胞

鏡檢
鏡檢緡錢狀紅細胞
在塗片上,紅細胞個個相連如一串緡錢,而是不散在分布。見於多發性骨髓瘤和免疫球蛋白增高等情況。
 紅細胞串錢狀
紅細胞串錢狀靶形紅細胞
陽性:地中海貧血、缺鐵性貧血、鐵粒幼紅細胞性貧血、阻塞性黃疸、肝病、脾切除後、家族性血清卵磷脂膽固醇轉醯酶缺乏症、血紅蛋白病(HbC、HbE、HbD、HbS)。
 靶形紅細胞
靶形紅細胞棘形紅細胞
棘形紅細胞是一種帶刺的紅細胞,刺呈針刺狀或尖刺狀。這種紅細胞見於:棘細胞增多症(血漿&beta。-脂蛋白缺乏症),可高達70-80%,其它也見於肝病及製片不當時,正常紅細胞也會變成棘細胞。 棘紅細胞
棘紅細胞嗜鹼性點彩紅細胞
增加:重金屬(鉛、汞銀、鉍)中毒有機化合物(硝基苯、苯胺)中毒明顯增加、溶血性貧血惡性貧血、白血病、惡性腫瘤小兒肺炎等亦增加健康搜尋。
嗜鹼性點彩
嗜鹼性點彩鐮形紅細胞
陽性:遺傳性鐮形紅細胞增多症,紅白血病 (急性紅細胞骨髓病;急非淋白血病;紅細胞增多症;紅血球增多;紅血性骨髓增生症;兒童真性紅細胞增多症;Di Guglielmo綜合徵;globulism;polycyth emia;erythrocytosis)
 鐮刀型紅細胞
鐮刀型紅細胞